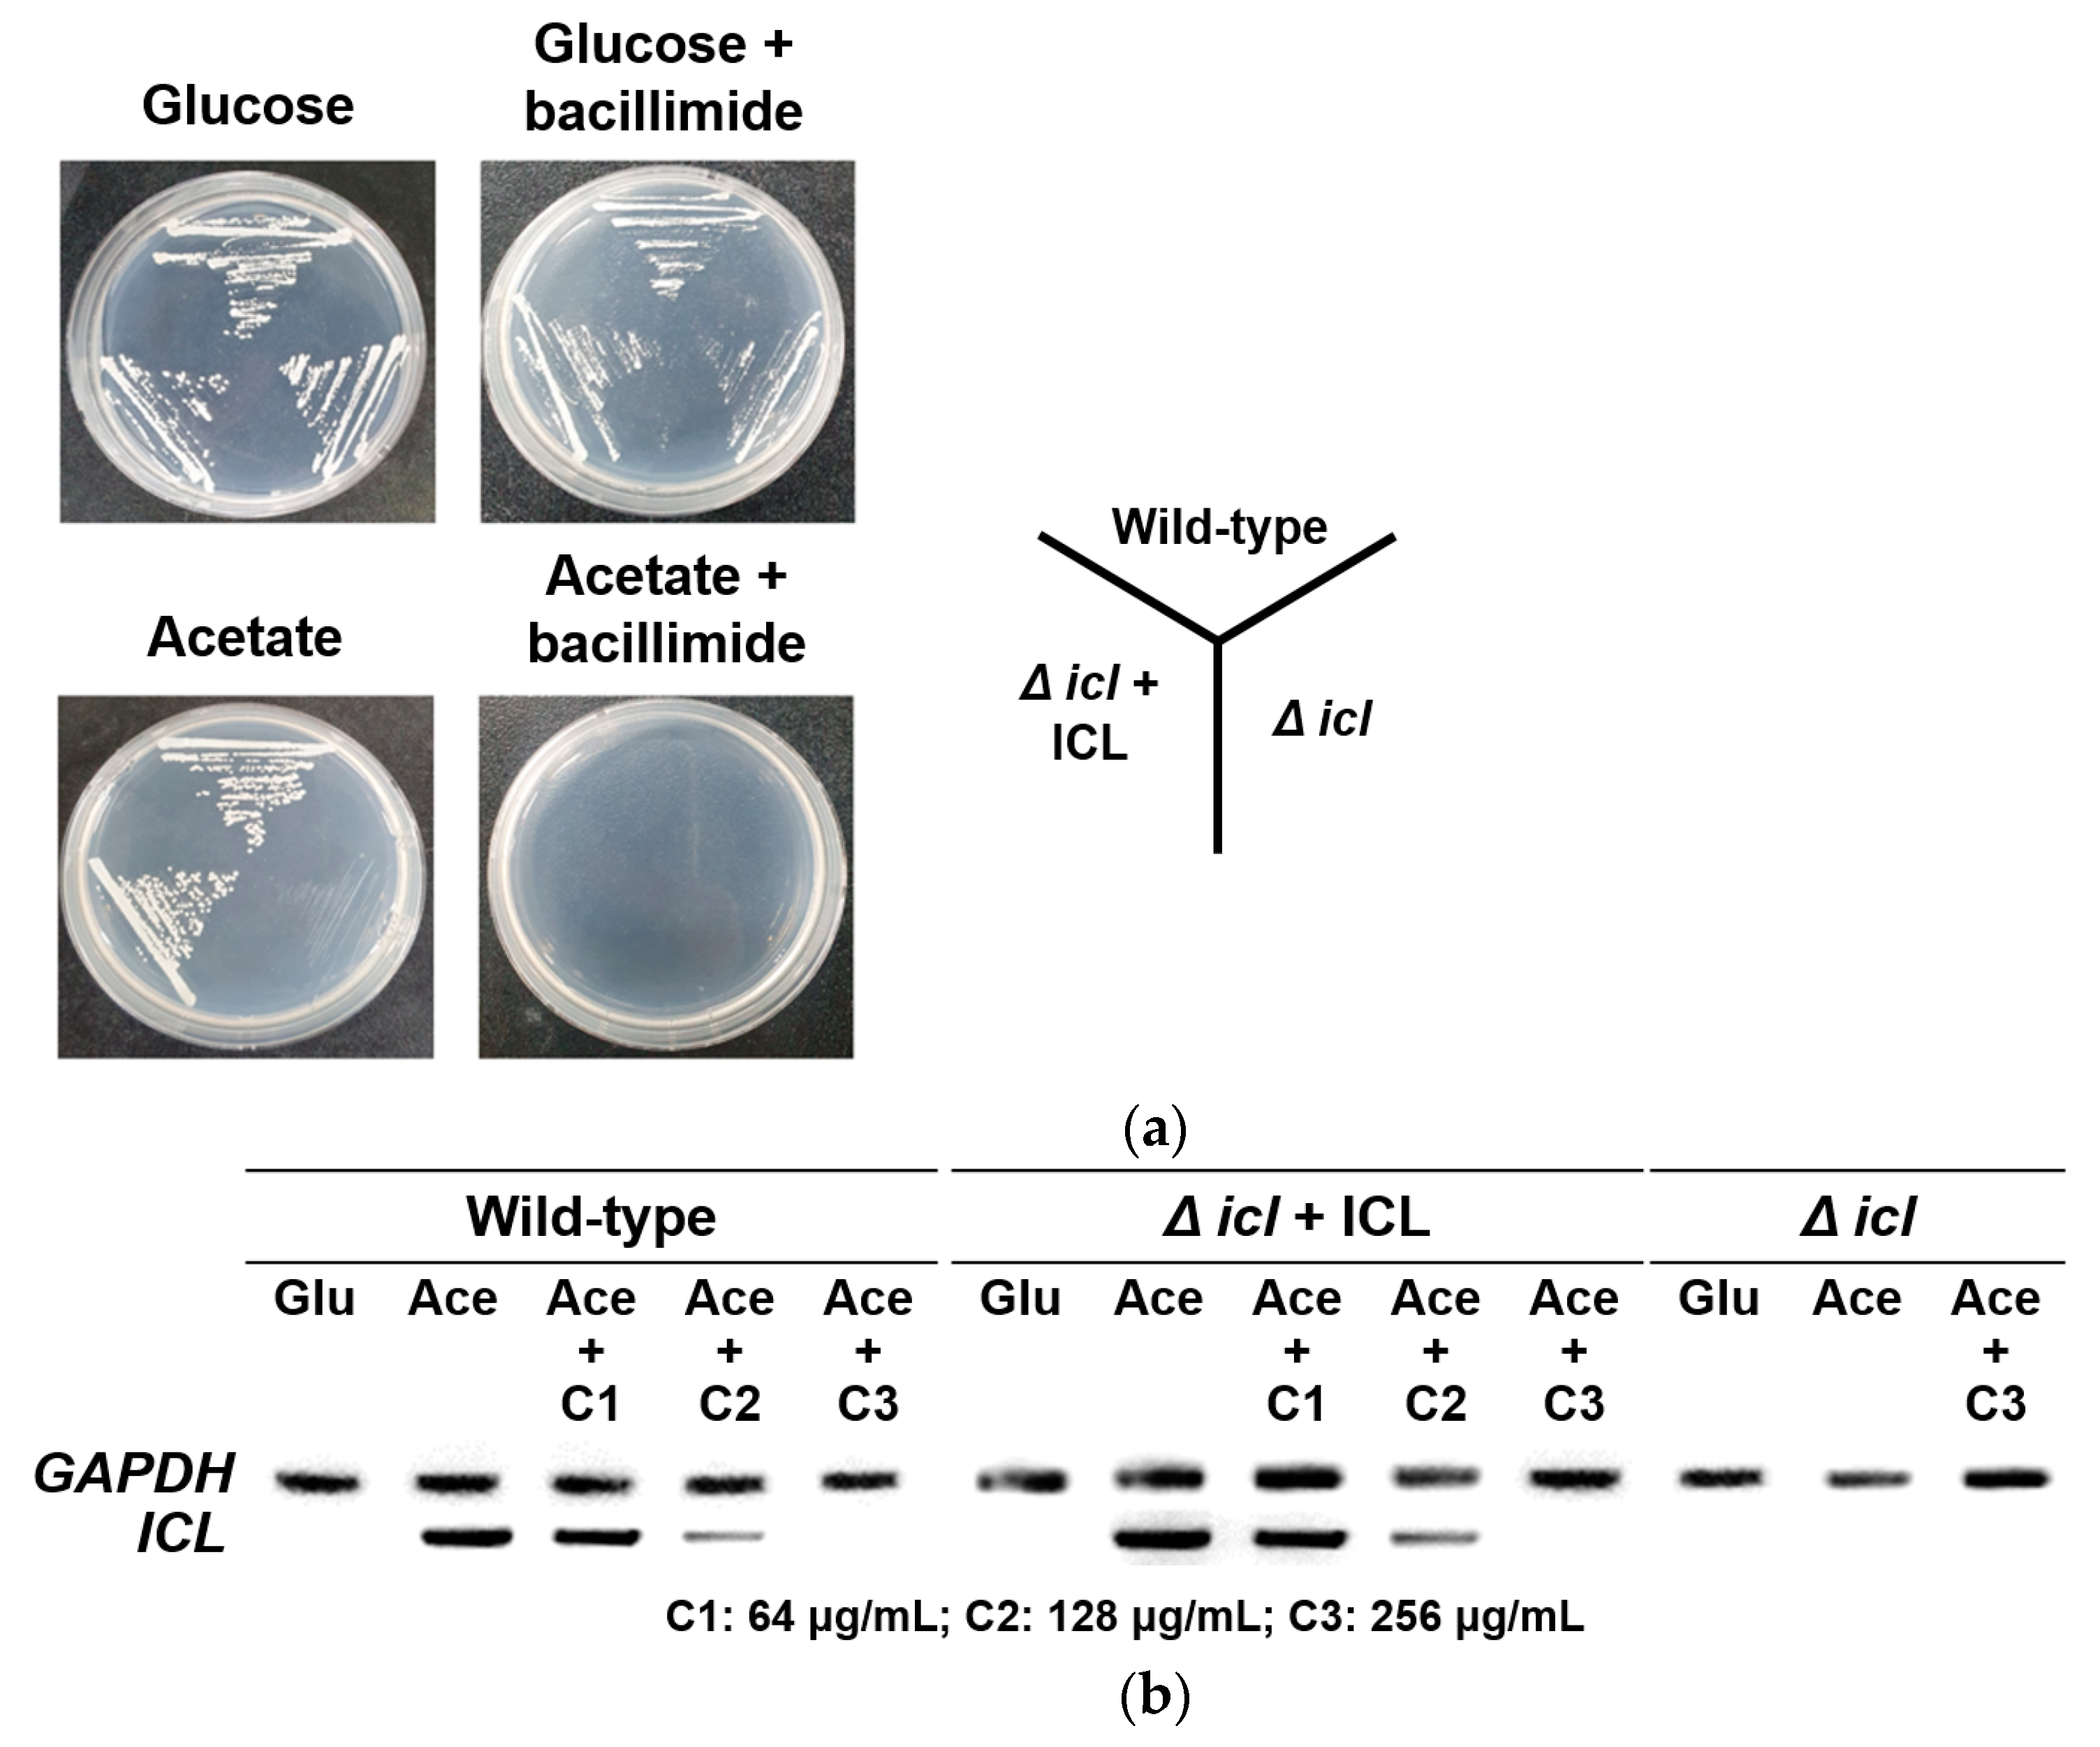
Marinedrugs 20 00138 g006 550

Inhibitory Effects of Nitrogenous Metabolites from a Marine-Derived Streptomyces bacillaris on Isocitrate Lyase of Candida albicans
Abstract
:1. Introduction
2. Results and Discussion
2.1. Structural Elucidation
2.2. ICL Inhibitory Activity and Antifungal Activity of Isolated Compounds
2.3. Inhibition of C2 Carbon Source Utilization
2.4. Effects of Bacillimide (1) on Growth Phenotype and icl Gene Expression
3. Materials and Methods
3.1. General Experimental Procedure
3.2. Taxonomic Identification and Fermentation
3.3. Extraction and Isolation
3.3.1. Bacillimide (1)
3.3.2. Bacillapyrrole (2)
3.4. Benzoylation of Compound 1
Benzoyl Bacillimide (1a)
3.5. Electronic Circular Dichroism (ECD) Calculations
3.6. ICL Inhibitory Activity Assay
3.7. In Vitro Growth Assay
3.8. Grow Phenotype and icl Expression Analysis
4. Conclusions
Supplementary Materials
Author Contributions
Funding
Institutional Review Board Statement
Data Availability Statement
Conflicts of Interest
References
- Vanni, P.; Giachetti, E.; Pinzauti, G.; McFadden, B.A. Comparative structure, function and regulation of isocitrate lyase, an important assimilatory enzyme. Comp. Biochem. Physiol. B 1990, 95, 431–458. [Google Scholar] [CrossRef]
- Dunn, M.F.; Ramirez-Trujillo, J.A.; Hernández-Lucas, I.; Dunn, M. Major roles of isocitrate lyase and malate synthase in bacterial and fungal pathogenesis. Microbiology 2009, 155, 3166–3175. [Google Scholar] [CrossRef] [PubMed] [Green Version]
- Kunze, M.; Pracharoenwattana, I.; Smith, S.M.; Hartig, A.A. Central role for the peroxisomal membrane in glyoxylate cycle function. Biochim. Biophys. Acta 2006, 1763, 1441–1452. [Google Scholar] [CrossRef] [PubMed] [Green Version]
- Strijbis, K.; Distel, B. Intracellular acetyl unit transport in fungal carbon metabolism. Eukaryot. Cell 2010, 9, 1809–1815. [Google Scholar] [CrossRef] [Green Version]
- Goldstein, A.L.; McCusker, J.H. Development of Saccharomyces cerevisiae as a model pathogen: A system for the genetic identification of gene products required for survival in the mammalian host environment. Genetics 2001, 159, 499–513. [Google Scholar] [CrossRef] [PubMed]
- Lorenz, M.C.; Fink, G.R. The glyoxylate cycle is required for fungal virulence. Nature 2001, 412, 83–86. [Google Scholar] [CrossRef]
- Ramirez, M.A.; Lorenz, M.C. Mutations in alternative carbon utilization pathways in Candida albicans attenuate virulence and confer pleiotropic phenotypes. Eukaryot. Cell 2007, 6, 280–290. [Google Scholar] [CrossRef] [Green Version]
- Katritzky, A.R.; Rees, C.W.; Scriven, E.F. Comprehensive Heterocyclic Chemistry II, 3rd ed.; Elsevier Science: Amsterdam, The Netherlands, 1996. [Google Scholar]
- Bhardwaj, V.; Gumber, D.; Abbot, V.; Dhiman, S.; Sharma, P. Pyrrole: A resourceful small molecule in key medicinal hetero-aromatics. RSC Adv. 2015, 5, 15233–15266. [Google Scholar] [CrossRef]
- Gholap, S.S. Pyrrole: An emerging scaffold for construction of valuable therapeutic agents. Eur. J. Med. Chem. 2016, 110, 13–31. [Google Scholar] [CrossRef]
- Ahmad, S.; Alam, O.; Naim, M.J.; Shaquiquzzaman, M.; Alam, M.M.; Iqbal, M. Pyrrole: An insight into recent pharmacological advances with structure activity relationship. Eur. J. Med. Chem. 2018, 157, 527–561. [Google Scholar] [CrossRef]
- Chen, C.; Zhu, H.; Wang, J.; Yang, J.; Li, X.N.; Wang, J.; Chen, K.; Wang, Y.; Luo, Z.; Yao, G.; et al. Armochaetoglobins K-R, anti-HIV pyrrole-based cytochalasans from Chaetomium globosum TW1-1. Eur. J. Org. Chem. 2015, 2015, 3086–3094. [Google Scholar] [CrossRef]
- Chen, S.; Yong, T.; Xiao, C.; Su, J.; Zhang, Y.; Jiao, C.; Su, J.; Zhang, Y.; Jiao, C.; Xie, Y. Pyrrole alkaloids and ergosterols from Grifola frondosa exert anti-α-glucosidase and anti-proliferative activities. J. Funct. Foods 2018, 43, 196–205. [Google Scholar] [CrossRef]
- La Regina, G.; Bai, R.; Coluccia, A.; Famiglini, V.; Pelliccia, S.; Passacantilli, S.; Mazzoccoli, C.; Ruggieri, V.; Sisinni, L.; Bolognesi, A.; et al. New pyrrole derivatives with potent tubulin polymerization inhibiting activity as anticancer agents including hedgehog-dependent cancer. J. Med. Chem. 2014, 57, 6531–6552. [Google Scholar] [CrossRef]
- Özdemir, A.; Altıntop, M.D.; Sever, B.; Gençer, H.K.; Kapkaç, H.A.; Atlı, Ö.; Baysal, M. A new series of pyrrole-based chalcones: Synthesis and evaluation of antimicrobial activity, cytotoxicity, and genotoxicity. Molecules 2017, 22, 2112. [Google Scholar] [CrossRef] [Green Version]
- Mohamed, M.S.; Abd El-Hameed, R.H.; Sayed, A.I.; Soror, S.H. Novel antiviral compounds against gastroenteric viral infections. Arch. Pharm. 2015, 348, 194–205. [Google Scholar] [CrossRef] [PubMed]
- Indumathi, S.; Karthikeyan, R.; Nasser, A.J.A.; Idhayadhulla, A.; Kumar, R.S. Anticonvulsant, analgesic and anti-inflammatory activities of some novel pyrrole and 1, 4-dihydropyridine derivatives. J. Chem. Pharm. Res. 2015, 7, 434–440. [Google Scholar]
- Pacorel, B.; Leung, S.C.; Stachulski, A.V.; Davies, J.; Vivas, L.; Lander, H.; Ward, S.A.; Kaise, M.; Brun, R.; O’Neill, P.M. Modular synthesis and in vitro and in vivo antimalarial assessment of C-10 pyrrole mannich base derivatives of artemisinin. J. Med. Chem. 2010, 53, 633–640. [Google Scholar] [CrossRef]
- Chung, B.; Kwon, O.-S.; Shin, J.; Oh, K.-B. Antibacterial activity and mode of action of lactoquinomycin A from Streptomyces bacillaris. Mar. Drugs 2021, 19, 7. [Google Scholar] [CrossRef]
- Yang, A.; Si, L.; Shi, Z.; Tian, L.; Liu, D.; Zhou, D.; Proksch, P.; Lin, W. Nitrosporeusines A and B, unprecedented thioester-bearing alkaloids from the Arctic Streptomyces nitrosporeus. Org. Lett. 2013, 15, 5366–5369. [Google Scholar] [CrossRef]
- Tsukamoto, S.; Tane, K.; Ohta, T.; Matsunaga, S.; Fusetani, N.; van Soest, R.W.M. Four new bioactive pyrrole-derived alkaloids from the marine sponge Axinellabrevistyla. J. Nat. Prod. 2001, 64, 1576–1578. [Google Scholar] [CrossRef]
- Said Fatahala, S.; Hasabelnaby, S.; Goudah, A.; Mahmoud, G.I.; Helmy Abd-El Hameed, R. 2017. Pyrrole and fused pyrrole compounds with bioactivity against inflammatory mediators. Molecules 2017, 22, 461. [Google Scholar] [CrossRef] [PubMed] [Green Version]
- Philkhana, S.C.; Verma, A.K.; Jachak, G.R.; Hazra, B.; Basu, A.; Reddy, D.S. Identification of new anti-inflammatory agents based on nitrosporeusine natural products of marine origin. Eur. J. Med. Chem. 2017, 135, 89–109. [Google Scholar] [CrossRef]
- Sugiyama, Y.; Watanabe, K.; Hirota, A. Surugapyrroles A and B, two new N-hydroxypyrroles as DPPH radical-scavengers from Streptomyces sp. USF-6280 strain. Biosci. Biotechnol. Biochem. 2009, 73, 230–232. [Google Scholar] [CrossRef] [PubMed]
- Shin, D.S.; Kim, S.; Yang, H.C.; Oh, K.-B. 2005. Cloning and expression of isocitrate lyase, a key enzyme of the glyoxylate cycle, of Candida albicans for development of antifungal drugs. J. Microbiol. Biotechnol. 2005, 15, 652–655. [Google Scholar]
- Dixon, G.H.; Kornberg, H.L. Assay methods for key enzymes of the glyoxylate cycle. Biochem. J. 1959, 72, 3. [Google Scholar]
- Hautzel, R.; Anke, H.; Sheldrick, W.S. Mycenon, a new metabolite from a Mycena species TA 87202 (basidiomycetes) as an inhibitor of isocitrate lyase. J. Antibiot. 1990, 43, 1240–1244. [Google Scholar] [CrossRef] [PubMed] [Green Version]
- Sharma, V.; Sharma, S.; Hönor zu Bentrup, K.; McKinney, J.D.; Russell, D.G.; Jacobs, W.R., Jr.; Sacchettini, J.C. Structure of isocitrate lyase, a persistence factor of Mycobacterium tuberculosis. Nat. Genet. 2000, 7, 663–668. [Google Scholar] [CrossRef]
- Clinical and Laboratory Standards Institute. Reference Methods for Broth Dilution Antifungal Susceptibility Testing of Yeasts, 4th ed.; M27; CLSI: Wayne, PA, USA, 2017. [Google Scholar]
- McKinney, J.D.; Hönor zu Bentrup, K.; Muñoz-Elías, E.J.; Miczak, A.; Chen, B.; Chan, W.T.; Swenson, D.; Sacchettini, J.C.; Jacobs, W.R., Jr.; Russell, D.G. Persistence of Mycobacterium tuberculosis in macrophages and mice requires the glyoxylate shunt enzyme isocitrate lyase. Nature 2000, 406, 735–738. [Google Scholar] [CrossRef]

| No. | 1 a | 2 b | ||
|---|---|---|---|---|
| δC, Type | δH (J in Hz) | δC, Type | δH (J in Hz) | |
| 2 | 179.4, C | 121.4, CH | 6.83, d (1.5) | |
| 3 | 57.0, C | 108.6, CH | 6.07, t (2.0) | |
| 4 | 33.7, CH2 | 2.18, ddd (13.0, 6.5, 1.5) | 110.0, CH | 6.74, d (1.5) |
| 2.07, dd (13.0, 6.0) | ||||
| 5 | 33.6, CH2 | 1.76, ddd (13.5, 6.5, 1.5) | 126.0, C | |
| 1.50, ddd (13.0, 7.0, 2.5) | ||||
| 6 | 74.2, CH | 4.26, br s | 160.8, C | |
| 7 | 62.4, CH | 2.85, s | ||
| 8 | 176.4, C | 32.6, CH2 | 3.60, ddd (14.0, 6.0, 1.5) | |
| 3.52, ddd (14.0, 7.0, 1.5) | ||||
| 9 | 12.5, CH3 | 2.14, s | 53.6, CH2 | 3.00, ddd (13.0, 6.5, 1.0) |
| 2.86, ddd (13.0, 6.0, 1.0) | ||||
| 10 | 38.1, CH3 | 2.58, s | ||
| 1-NH | 11.49, br s | 11.45, br s | ||
| 6-OH | 5.28, s | |||
| 7-NH | 8.26, t (4.5) | |||
| Compound | ICL IC50 (μM) | MIC (μM) in Glucose |
|---|---|---|
| Bacillimide (1) | 44.24 ± 1.05 | >1273.64 |
| Bacillapyrrole (2) | 190.45 ± 3.86 | >1280.00 |
| 3-Nitropropionate | 21.49 ± 0.97 | >2149.46 |
| Amphotericin B | ND | 0.5 |
| Strain | MIC (μg/mL) | |||
|---|---|---|---|---|
| Glucose | Acetate | |||
| Bacillimide (1) | Amph B 1 | Bacillimide (1) | Amph B 1 | |
| SC5314 | >1024 | 0.5 | 256 | 0.5 |
| ATCC10231 | >1024 | 0.5 | 256 | 0.5 |
| ATCC10259 | >1024 | 0.5 | 256 | 0.5 |
| ATCC11006 | >1024 | 1 | 256 | 0.5 |
| ATCC18804 | >1024 | 1 | 256 | 1 |
Publisher’s Note: MDPI stays neutral with regard to jurisdictional claims in published maps and institutional affiliations. |
© 2022 by the authors. Licensee MDPI, Basel, Switzerland. This article is an open access article distributed under the terms and conditions of the Creative Commons Attribution (CC BY) license (https://creativecommons.org/licenses/by/4.0/).
Share and Cite
Chung, B.; Hwang, J.-Y.; Park, S.C.; Kwon, O.-S.; Cho, E.; Lee, J.; Lee, H.-S.; Oh, D.-C.; Shin, J.; Oh, K.-B. Inhibitory Effects of Nitrogenous Metabolites from a Marine-Derived Streptomyces bacillaris on Isocitrate Lyase of Candida albicans. Mar. Drugs 2022, 20, 138. https://doi.org/10.3390/md20020138
Chung B, Hwang J-Y, Park SC, Kwon O-S, Cho E, Lee J, Lee H-S, Oh D-C, Shin J, Oh K-B. Inhibitory Effects of Nitrogenous Metabolites from a Marine-Derived Streptomyces bacillaris on Isocitrate Lyase of Candida albicans. Marine Drugs. 2022; 20(2):138. https://doi.org/10.3390/md20020138
Chicago/Turabian StyleChung, Beomkoo, Ji-Yeon Hwang, Sung Chul Park, Oh-Seok Kwon, Eunji Cho, Jayho Lee, Hyi-Seung Lee, Dong-Chan Oh, Jongheon Shin, and Ki-Bong Oh. 2022. "Inhibitory Effects of Nitrogenous Metabolites from a Marine-Derived Streptomyces bacillaris on Isocitrate Lyase of Candida albicans" Marine Drugs 20, no. 2: 138. https://doi.org/10.3390/md20020138
APA StyleChung, B., Hwang, J.-Y., Park, S. C., Kwon, O.-S., Cho, E., Lee, J., Lee, H.-S., Oh, D.-C., Shin, J., & Oh, K.-B. (2022). Inhibitory Effects of Nitrogenous Metabolites from a Marine-Derived Streptomyces bacillaris on Isocitrate Lyase of Candida albicans. Marine Drugs, 20(2), 138. https://doi.org/10.3390/md20020138






